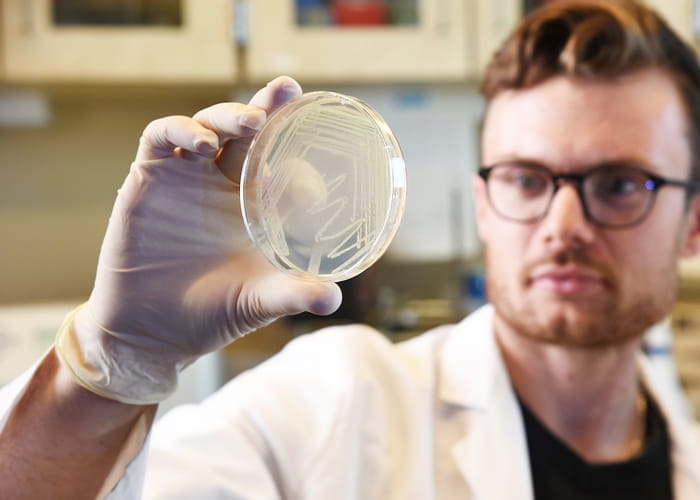

Planned for Summer 2025
We train Indiana’s doctors. We transform care through revolutionary research. And for more than a century, we have been essential for healthy Hoosiers. Now, Indiana University School of Medicine needs room to grow, innovate, and teach. Our new home in Indianapolis will be equipped with the classrooms, labs, technology, and expertise to uncover answers to medicine’s most challenging problems.